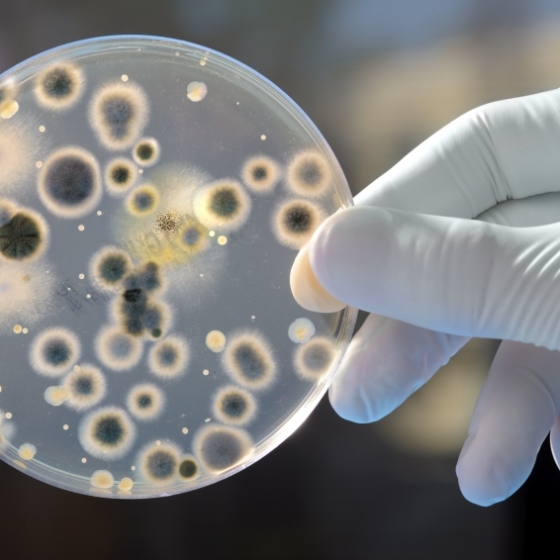

Zdravlje
Velika studija potvrdila ‘savršenu oluju’ faktora koji uzrokuju razne alergije

Hrana i recepti
7 užina koje će vam podići energiju bolje od kave

Ljepota
Jeste li čuli za ‘tamno tuširanje’? Novi trend koji smiruje tijelo i um prije spavanja
Istaknute teme
Halo, doktore!
Vi pitate,naši liječnici odgovaraju.

Ginekologija
Kako povećati šanse za trudnoću nakon spontanog pobačaja?
Odgovara:
dr.sc. Jasenka Grujić, ginekologinja

Dermatologija
Postoje li minimalno invazivne metode za uklanjanje lipoma osim kirurgije?
Odgovara:
Dr. sci. Ivana Ručević, dr. med., spec. dermatologije i venerologije

Urologija
Što uzrokuje crvenilo i prištiće na glavici penisa i trebam li posjetiti liječnika?
Odgovara:
Mr. sc. Antonio Plešnar, Spec.Urolog i subspecijalsita Urološke Onokologije

Ginekologija
Koji su mogući uzroci bolova u zdjelici nakon operacije mioma?
Odgovara:
Matilda Mladinić, dr. med., spec. ginekologije i porodništva, Croatia poliklinike u Splitu

Urologija
Zašto mi se prostata naglo povećala unatoč urednom PSA-u?
Odgovara:
Mr. sc. Antonio Plešnar, Spec.Urolog i subspecijalsita Urološke Onokologije
Zdravstveni adresar
S lakoćom pronađite ordinaciju, ljekarnu, polikliniku i drugo.
Baza bolesti
Nešto vas boli ili smeta? Prije odlaska liječniku možete se informirati ovdje.
Srcoljubac
Novosti
Zdravlje
Svi članci
Bakterije zamrznute 5.000 godina mogle bi promijeniti borbu protiv otpornosti na antibiotike
Psiha
Svi članci
Psihologija mirisa: Evo što odabir parfema otkriva o vašoj osobnosti, emocionalnim potrebama i unutarnjem stanju
Brain TALK

Generacija koja pati u tišini: Vrijeme je za promjenu pristupa mentalnom zdravlju

Švedska je u osnovne škole uvela programe emocionalne inteligencije, a terapijske usluge su besplatne za mlade

Kako influenceri mijenjaju percepciju mentalnog zdravlja u svijetu?

Roditelji imaju ključnu ulogu u očuvanju mentalnog zdravlja djece no važno je da savršena obiteljska slika nije “samo za javnost”
Ljepota
Svi članci


























